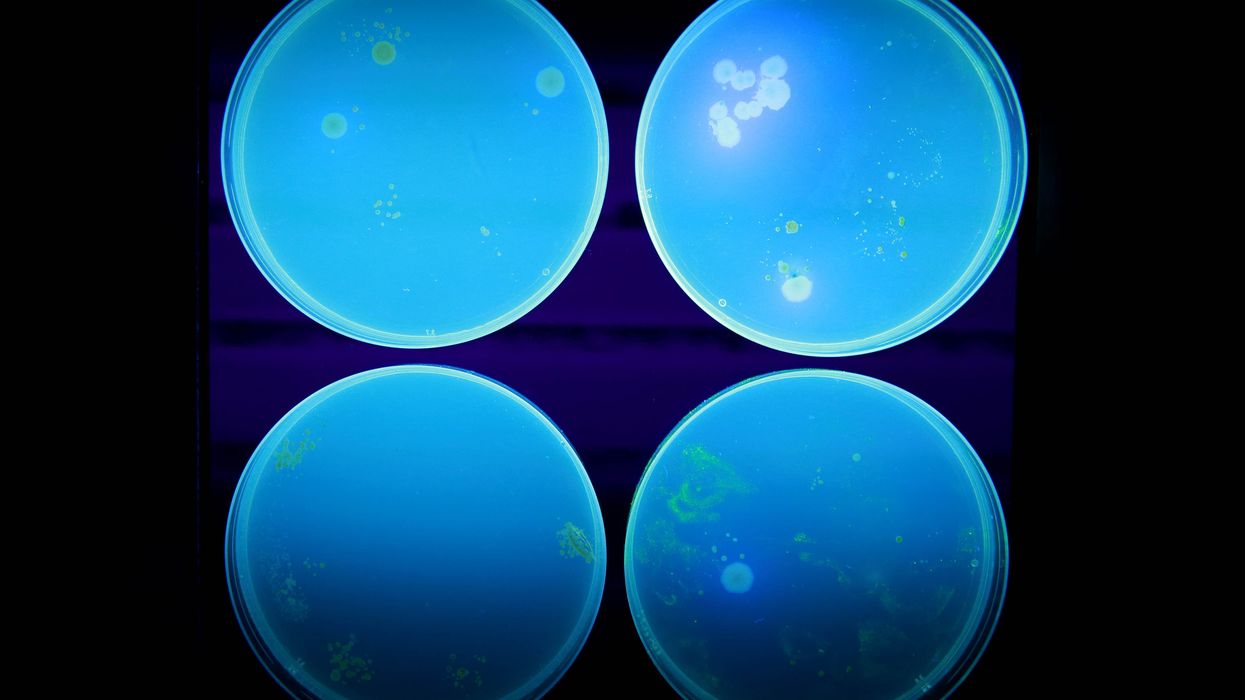
E.coli

E.coli: One person dies after major outbreak, UKHSA says
One person has died after a major E.Coli outbreak
| PA
Supermarkets have been recalling products over fears of contamination
Don't Miss
Most Read
Latest
One person in England has died linked to the ongoing E.coli outbreak, the UK Health Security Agency (UKHSA) has said.
In a statement, the UKHSA confirmed that one person with an "underlying medical condition" had died in May after contracting the shiga toxin-producing E.coli (Stec).
The Government body said it had identified two people in England who died within 28 days of infection with Stec.
“Based on the information available from health service clinicians one of these deaths is likely linked to their Stec infection,” it said.
One person has died after a major E.Coli outbreak | PA“Both individuals had underlying medical conditions. The deaths occurred in May.”
Health officials have been working to track down the source of a current outbreak, which is thought to be related to some pre-packed sandwiches containing lettuce.
This particular strain of the bacteria can make people seriously unwell.
As of June 25, there have been a further 19 cases of Stec, bringing the total number of confirmed cases to 275 in the UK.
LATEST DEVELOPMENTS:
Several products have been pulled from supermarket shelves over fears of contamination with E.coli | GETTYThree companies have pulled their products from major supermarkets and retail chains over fears of contamination.
Last week, the Food Standards Agency (FSA) said manufacturer THIS! has issued a recall notice to customers over its vegan chicken and bacon wrap, which is sold only at WH Smith.
The agency said anyone who purchased the product at any point up to and including June 18, should not eat it and instead return it to the store for a full refund.
It is the third company to pull a product, after manufacturers Greencore Group and Samworth Brothers Manton Wood also recalled a variety of sandwiches, wraps and salads sold in major UK supermarkets.
Darren Whitby, Head of Incidents at the FSA said: "Earlier this month, we confirmed that several sandwich manufacturers had taken precautionary action to withdraw and recall various sandwiches, wraps, subs and rolls after food chain and epidemiological links enabled us to narrow down a wide range of foods to a type of lettuce used in sandwich products as the likely cause of the outbreak.
Lettuce leaves are thought to be behind the current E.coli outbreak | Getty Imagess "This remains a complex investigation and we continue to work with the relevant businesses and the local authorities to ensure necessary steps are being taken to protect consumers. Although we are confident in the likely source of the outbreak being linked to lettuce, work continues to confirm this and identify the root cause of the outbreak with the growers, suppliers and manufacturers so that actions can be taken to prevent a re-occurrence."
E. coli are a diverse group of bacteria that normally live in human and animal intestines.
Some types are harmless but others can make people seriously ill, including Stec, which attacks the lining of the stomach.
Symptoms include diarrhoea, stomach cramps and fever. About 50 per cent of cases can develop bloody diarrhoea.









